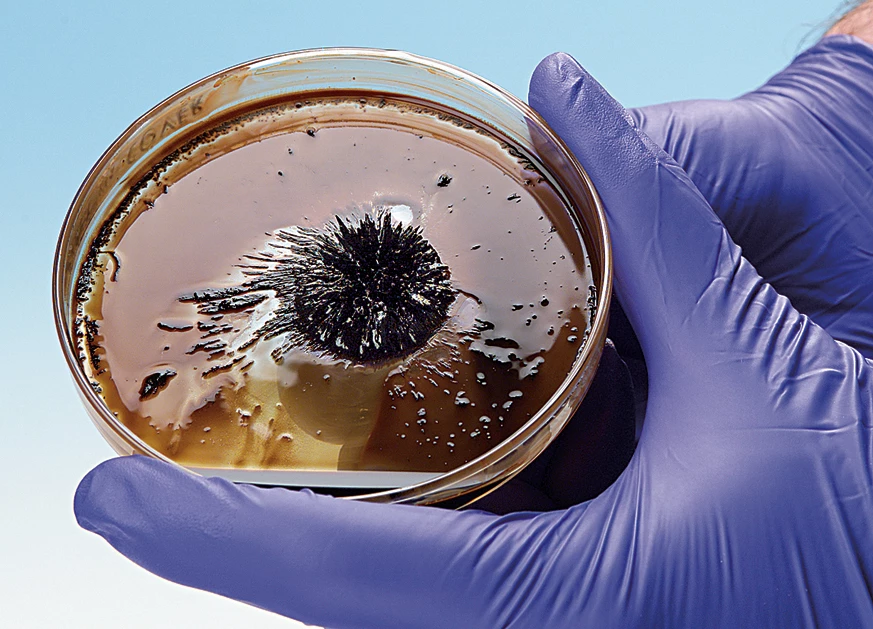
Ferrofluid Nanotechnology—Chemical Demonstration Kit 1 Ferrofluid Nanotechnology—Chemical Demonstration Kit

Product Details
A magnetic liquid, also known as a ferrofluid, may seem like a space-age concept. That’s because it is! Now you can prepare a ferrofluid and demonstrate the concept that was invented by NASA in the 1960s to control liquids in space. The procedure is remarkably simple. Magnetite (Fe3O4) is prepared by combining Fe2+ and Fe3+ ions with a weak base in dilute aqueous solution. The resulting magnetite particles are extremely small nanoparticles. Shrinking the size of solid-phase particles to the nanometer scale—one-billionth of a meter—radically changes their physical and chemical properties. Rather than settle out as a solid, the magnetite particles remain suspended in the aqueous medium, giving rise to a magnetic liquid! Place a magnet under the liquid in a Petri dish or vial, and the liquid will form dramatic spikes. Nanotechnology may well be the next “big thing” in science—pun intended. Update your curriculum today! Enough materials are included to perform the demonstration seven times.
Concepts: Ferrimagnetic substances and magnetic properties, colloids vs. solutions, nanotechnology.
Time Required: 10 minutes
Materials Provided: Iron(II) chloride and iron(III) chloride, ammonia solution, tetramethylammonium hydroxide solution, hydrochloric acid solution, neodymium magnet, Pasteur pipets, and weighing dishes.
Note: Perform this demonstration in a fume hood or well-ventilated lab.

Reviews
There are no reviews yet.